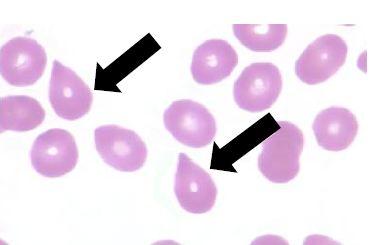

หน้าหลัก | สุขภาพดี | สุภาพสตรี | การแปลผลเลือด | โรคต่างๆ | ยารักษาโรค |วัคซีน | อาหารเพื่อสุขภาพ
เซลล์เม็ดเลือดแดง Tear drop cell
Tear drop cell เป็นเซลล์รูปร่างเหมือนหยดน้ำ สันนิษฐานว่าเกิดจากม้าม เมื่อเม็ดเลือดแดงที่ไม่สมบูรณ์มี inclusion bodies ซึ่งเกิดจากการตกตะกอนของ Hb หรือฮีโมโกลบินถูกออกซิไดส์ จะถูกม้ามจัดการ เซลล์เม็ดเลือดแดงมักจะตัวเล็ก และมีhemoglobin น้อย hopochromasia
สาเหตุใดของ Tear drop cell
Hemoglobin | Hematocrit | Red blood cell | Inclusion body | เม็ดเลือดแดง | Reticulocyte count | MCV | MCHC | MCH | ลักษณะเม็ดเลือดแดง | เกล็ดเลือด | เม็ดเลือดขาว | Neutrophil | Lymphocyte | Eosinophil | Monocyte | Basophil | Rh | กรุปเลือด